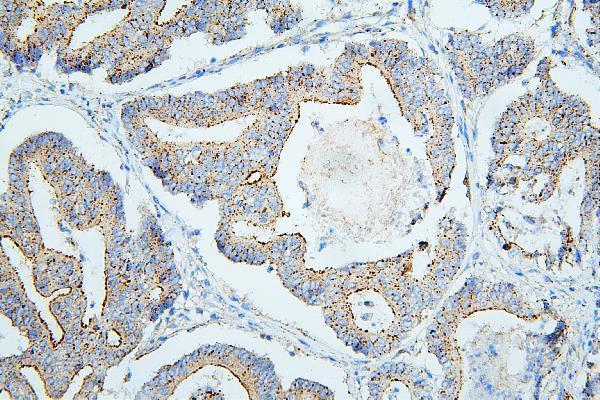
m01751 1 pdcd6ip primary antibodies ihc testing 4

Product Info Summary
| SKU: | M01751-1 |
|---|---|
| Size: | 100 μg/vial |
| Reactive Species: | Human, Mouse, Rat |
| Host: | Mouse |
| Application: | Flow Cytometry, IF, IHC, ICC, WB |
Customers Who Bought This Also Bought
Product info
Product Name
Anti-ALIX/PDCD6IP Antibody Picoband®(monoclonal, 14D10)
SKU/Catalog Number
M01751-1
Size
100 μg/vial
Form
Lyophilized
Description
Boster Bio Anti-ALIX/PDCD6IP Antibody Picoband® (monoclonal, 14D10) catalog # M01751-1. Tested in Flow Cytometry, IF, IHC, ICC, WB applications. This antibody reacts with Human, Mouse, Rat. The brand Picoband indicates this is a premium antibody that guarantees superior quality, high affinity, and strong signals with minimal background in Western blot applications. Only our best-performing antibodies are designated as Picoband, ensuring unmatched performance.
Storage & Handling
Store at -20˚C for one year from date of receipt. After reconstitution, at 4˚C for one month. It can also be aliquotted and stored frozen at -20˚C for six months. Avoid repeated freeze-thaw cycles.
Cite This Product
Anti-ALIX/PDCD6IP Antibody Picoband®(monoclonal, 14D10) (Boster Biological Technology, Pleasanton CA, USA, Catalog # M01751-1)
Host
Mouse
Contents
Each vial contains 4mg Trehalose, 0.9mg NaCl, 0.2mg Na2HPO4, 0.05mg NaN3.
Clonality
Monoclonal
Clone Number
14D10
Isotype
Mouse IgG2b
Immunogen
E.coli-derived human PDCD6IP recombinant protein (Position: A2-D330). Human PDCD6IP shares 96.7% and 95.2% amino acid (aa) sequence identity with mouse and rat PDCD6IP, respectively.
Cross-reactivity
No cross-reactivity with other proteins.
Reactive Species
M01751-1 is reactive to PDCD6IP in Human, Mouse, Rat
Observed Molecular Weight
96-100 kDa
Calculated molecular weight
96.0 kDa
Background of PDCD6IP
Programmed cell death 6-interacting protein is a protein that in humans is encoded by the PDCD6IP gene. This gene encodes a protein that functions within the ESCRT pathway in the abscission stage of cytokinesis, in intralumenal endosomal vesicle formation, and in enveloped virus budding. Studies using mouse cells have shown that overexpression of this protein can block apoptosis. In addition, the product of this gene binds to the product of the PDCD6 gene, a protein required for apoptosis, in a calcium-dependent manner. This gene product also binds to endophilins, proteins that regulate membrane shape during endocytosis. Overexpression of this gene product and endophilins results in cytoplasmic vacuolization, which may be partly responsible for the protection against cell death. Several alternatively spliced transcript variants encoding different isoforms have been found for this gene.
Antibody Validation
Boster validates all antibodies on WB, IHC, ICC, Immunofluorescence, and ELISA with known positive control and negative samples to ensure specificity and high affinity, including thorough antibody incubations.
Application & Images
Applications
M01751-1 is guaranteed for Flow Cytometry, IF, IHC, ICC, WB Boster Guarantee
Recommend Dilution
| Application | Dilution | Species |
|---|---|---|
| "Western blot | 0.1-0.5μg/ml | Human, Mouse, Rat |
| Immunohistochemistry (Paraffin-embedded Section) | 0.5-1μg/ml | Human, Mouse, Rat |
| Immunocytochemistry/Immunofluorescence | 2μg/ml | Human |
| Flow Cytometry (Fixed) | 1-3μg/1x106 | Human |
Tested application
Suggested blocking solution with 5% non-fat milk or BSA; (*)Recommended protein loading: 20-40 µg per lane
Use TE buffer pH 9.0 for antigen retrieval; (*) citrate buffer pH 6.0 is an alternative.
Validation Images & Assay Conditions

Click image to see more details
Western blot analysis of PDCD6IP using anti-PDCD6IP antibody (M01751-1).
Electrophoresis was performed on a 5-20% SDS-PAGE gel at 70V (Stacking gel) / 90V (Resolving gel) for 2-3 hours. The sample well of each lane was loaded with 50ug of sample under reducing conditions.
Lane 1: human Hela whole cell lysates
Lane 2: human HepG2 whole cell lysates
Lane 3: human Jurkat whole cell lysates
Lane 4: human PANC-1 whole cell lysates
Lane 5: human K562 whole cell lysates
Lane 6: human SW579 whole cell lysates
Lane 7: rat RH35 whole cell lysates
Lane 8: mouse NIH3T3 whole cell lysates
After Electrophoresis, proteins were transferred to a Nitrocellulose membrane at 150mA for 50-90 minutes. Blocked the membrane with 5% Non-fat Milk/ TBS for 1.5 hour at RT. The membrane was incubated with mouse anti-PDCD6IP antigen affinity purified monoclonal antibody (Catalog # M01751-1) at 0.5 μg/mL overnight at 4°C, then washed with TBS-0.1%Tween 3 times with 5 minutes each and probed with a goat anti-mouse IgG-HRP secondary antibody at a dilution of 1:10000 for 1.5 hour at RT. The signal is developed using an Enhanced Chemiluminescent detection (ECL) kit (Catalog # EK1001) with Tanon 5200 system. A specific band was detected for PDCD6IP at approximately 96-100KD. The expected band size for PDCD6IP is at 96KD.

Click image to see more details
IHC analysis of PDCD6IP using anti-PDCD6IP antibody (M01751-1).
PDCD6IP was detected in paraffin-embedded section of human mammary cancer tissue. Heat mediated antigen retrieval was performed in citrate buffer (pH6, epitope retrieval solution) for 20 mins. The tissue section was blocked with 10% goat serum. The tissue section was then incubated with 1μg/ml mouse anti-PDCD6IP Antibody (M01751-1) overnight at 4°C. Biotinylated goat anti-mouse IgG was used as secondary antibody and incubated for 30 minutes at 37°C. The tissue section was developed using Strepavidin-Biotin-Complex (SABC)(Catalog # SA1021) with DAB as the chromogen.

Click image to see more details
IHC analysis of PDCD6IP using anti-PDCD6IP antibody (M01751-1).
PDCD6IP was detected in paraffin-embedded section of human intestinal cancer tissue. Heat mediated antigen retrieval was performed in citrate buffer (pH6, epitope retrieval solution) for 20 mins. The tissue section was blocked with 10% goat serum. The tissue section was then incubated with 1μg/ml mouse anti-PDCD6IP Antibody (M01751-1) overnight at 4°C. Biotinylated goat anti-mouse IgG was used as secondary antibody and incubated for 30 minutes at 37°C. The tissue section was developed using Strepavidin-Biotin-Complex (SABC)(Catalog # SA1021) with DAB as the chromogen.
Click image to see more details
IHC analysis of PDCD6IP using anti-PDCD6IP antibody (M01751-1).
PDCD6IP was detected in paraffin-embedded section of human intestinal cancer tissue. Heat mediated antigen retrieval was performed in citrate buffer (pH6, epitope retrieval solution) for 20 mins. The tissue section was blocked with 10% goat serum. The tissue section was then incubated with 1μg/ml mouse anti-PDCD6IP Antibody (M01751-1) overnight at 4°C. Biotinylated goat anti-mouse IgG was used as secondary antibody and incubated for 30 minutes at 37°C. The tissue section was developed using Strepavidin-Biotin-Complex (SABC)(Catalog # SA1021) with DAB as the chromogen.

Click image to see more details
IHC analysis of PDCD6IP using anti-PDCD6IP antibody (M01751-1).
PDCD6IP was detected in paraffin-embedded section of mouse testis tissue. Heat mediated antigen retrieval was performed in citrate buffer (pH6, epitope retrieval solution) for 20 mins. The tissue section was blocked with 10% goat serum. The tissue section was then incubated with 1μg/ml mouse anti-PDCD6IP Antibody (M01751-1) overnight at 4°C. Biotinylated goat anti-mouse IgG was used as secondary antibody and incubated for 30 minutes at 37°C. The tissue section was developed using Strepavidin-Biotin-Complex (SABC)(Catalog # SA1021) with DAB as the chromogen.

Click image to see more details
IHC analysis of PDCD6IP using anti-PDCD6IP antibody (M01751-1).
PDCD6IP was detected in paraffin-embedded section of rat testis tissue. Heat mediated antigen retrieval was performed in citrate buffer (pH6, epitope retrieval solution) for 20 mins. The tissue section was blocked with 10% goat serum. The tissue section was then incubated with 1μg/ml mouse anti-PDCD6IP Antibody (M01751-1) overnight at 4°C. Biotinylated goat anti-mouse IgG was used as secondary antibody and incubated for 30 minutes at 37°C. The tissue section was developed using Strepavidin-Biotin-Complex (SABC)(Catalog # SA1021) with DAB as the chromogen.

Click image to see more details
IHC analysis of PDCD6IP using anti-PDCD6IP antibody (M01751-1).
PDCD6IP was detected in paraffin-embedded section of rat testis tissue. Heat mediated antigen retrieval was performed in citrate buffer (pH6, epitope retrieval solution) for 20 mins. The tissue section was blocked with 10% goat serum. The tissue section was then incubated with 1μg/ml mouse anti-PDCD6IP Antibody (M01751-1) overnight at 4°C. Biotinylated goat anti-mouse IgG was used as secondary antibody and incubated for 30 minutes at 37°C. The tissue section was developed using Strepavidin-Biotin-Complex (SABC)(Catalog # SA1021) with DAB as the chromogen.

Click image to see more details
IF analysis of PDCD6IP using anti-PDCD6IP antibody (M01751-1).
PDCD6IP was detected in immunocytochemical section of U20S cells. Enzyme antigen retrieval was performed using IHC enzyme antigen retrieval reagent (AR0022) for 15 mins. The cells were blocked with 10% goat serum. And then incubated with 2μg/mL mouse anti-PDCD6IP Antibody (M01751-1) overnight at 4°C. DyLight488 Conjugated Goat Anti-Mouse IgG (BA1126) was used as secondary antibody at 1:100 dilution and incubated for 30 minutes at 37°C. The section was counterstained with DAPI. Visualize using a fluorescence microscope and filter sets appropriate for the label used.

Click image to see more details
Flow Cytometry analysis of A431 cells using anti-PDCD6IPantibody (M01751-1).
Overlay histogram showing A431 cells stained with M01751-1 (Blue line). To facilitate intracellular staining, cells were fixed with 4% paraformaldehyde and permeabilized with permeabilization buffer. The cells were blocked with 10% normal goat serum. And then incubated with mouse anti-PDCD6IP Antibody (M01751-1, 1μg/1x106 cells) for 30 min at 20°C. DyLight488 conjugated goat anti-mouse IgG (BA1126, 5-10μg/1x106 cells) was used as secondary antibody for 30 minutes at 20°C. Isotype control antibody (Green line) was mouse IgG (1μg/1x106) used under the same conditions. Unlabelled sample without incubation with primary antibody and secondary antibody (Red line) was used as a blank control.
Specific Publications For Anti-ALIX/PDCD6IP Antibody Picoband®(monoclonal, 14D10) (M01751-1)
Loading publications
Recommended Resources
Here are featured tools and databases that you might find useful.
- Boster's Pathways Library
- Protein Databases
- Bioscience Research Protocol Resources
- Data Processing & Analysis Software
- Photo Editing Software
- Scientific Literature Resources
- Research Paper Management Tools
- Molecular Biology Software
- Primer Design Tools
- Bioinformatics Tools
- Phylogenetic Tree Analysis
Customer Reviews
Have you used Anti-ALIX/PDCD6IP Antibody Picoband®(monoclonal, 14D10)?
Share your experimental results or join a short interview to earn up to $1,000 in product credits or other rewards.
0 Reviews For Anti-ALIX/PDCD6IP Antibody Picoband®(monoclonal, 14D10)
Customer Q&As
Have a question?
Find answers in Q&As, reviews.
Can't find your answer?
Submit your question
5 Customer Q&As for Anti-ALIX/PDCD6IP Antibody Picoband®(monoclonal, 14D10)
Question
My team were well pleased with the WB result of your anti-ALIX/PDCD6IP antibody(monoclonal, 14D10). However we have been able to see positive staining in melanoma cytoplasm using this antibody. Is that expected? Could you tell me where is PDCD6IP supposed to be expressed?
Verified Customer
Verified customer
Asked: 2019-11-04
Answer
From literature, melanoma does express PDCD6IP. Generally PDCD6IP expresses in cytoplasm, cytosol. Regarding which tissues have PDCD6IP expression, here are a few articles citing expression in various tissues:
Brain, Pubmed ID: 10718198
Cervix carcinoma, Pubmed ID: 18669648, 20068231
Cervix carcinoma, and Erythroleukemia, Pubmed ID: 23186163
Colon carcinoma, Pubmed ID: 24129315
Liver, Pubmed ID: 24275569
Lymph, and Testis, Pubmed ID: 15489334
Melanoma, Pubmed ID: 17081065
Placenta, Pubmed ID: 14702039
Boster Scientific Support
Answered: 2019-11-04
Question
We ordered your anti-ALIX/PDCD6IP antibody(monoclonal, 14D10) for IHC-P on cervix carcinoma erythroleukemia a few months ago. I am using rat, and We want to use the antibody for IF next. My question regards examining cervix carcinoma erythroleukemia as well as placenta in our next experiment. Could give a recommendation on which antibody would work the best for IF?
Verified Customer
Verified customer
Asked: 2018-12-31
Answer
I took a look at the website and datasheets of our anti-ALIX/PDCD6IP antibody(monoclonal, 14D10) and it appears that M01751-1 has been validated on rat in both IHC-P and IF. Thus M01751-1 should work for your application. Our Boster satisfaction guarantee will cover this product for IF in rat even if the specific tissue type has not been validated. We do have a comprehensive range of products for IF detection and you can check out our website bosterbio.com to find out more information about them.
Boster Scientific Support
Answered: 2018-12-31
Question
We are currently using anti-ALIX/PDCD6IP antibody(monoclonal, 14D10) M01751-1 for human tissue, and we are well pleased with the ICC results. The species of reactivity given in the datasheet says human, mouse, rat. Is it likely that the antibody can work on monkey tissues as well?
Verified Customer
Verified customer
Asked: 2018-03-07
Answer
The anti-ALIX/PDCD6IP antibody(monoclonal, 14D10) (M01751-1) has not been validated for cross reactivity specifically with monkey tissues, but there is a good chance of cross reactivity. We have an innovator award program that if you test this antibody and show it works in monkey you can get your next antibody for free. Please contact me if I can help you with anything.
Boster Scientific Support
Answered: 2018-03-07
Question
I was wanting to use using your anti-ALIX/PDCD6IP antibody(monoclonal, 14D10) for viral life cycle studies. Has this antibody been tested with western blotting on intestinal cancer tissue? We would like to see some validation images before ordering.
N. Huang
Verified customer
Asked: 2016-11-30
Answer
I appreciate your inquiry. This M01751-1 anti-ALIX/PDCD6IP antibody(monoclonal, 14D10) is validated on human hela, hela whole cell lysates, hepg2 whole cell lysates, jurkat whole cell lysates, k562 whole cell lysates, rat testis tissue, mouse testis tissue, nih3t3 whole cell lysates, mammary cancer tissue, intestinal cancer tissue, u20s cells, a431 cells. It is guaranteed to work for Flow Cytometry, IF, IHC-P, ICC, WB in human, mouse, rat. Our Boster guarantee will cover your intended experiment even if the sample type has not been be directly tested.
Boster Scientific Support
Answered: 2016-11-30
Question
We have observed staining in human cervix carcinoma. What should we do? Is anti-ALIX/PDCD6IP antibody(monoclonal, 14D10) supposed to stain cervix carcinoma positively?
M. Banerjee
Verified customer
Asked: 2015-11-04
Answer
According to literature cervix carcinoma does express PDCD6IP. According to Uniprot.org, PDCD6IP is expressed in corpus callosum, lymph testis, osteosarcoma, placenta, brain, melanoma, cervix carcinoma, cervix carcinoma erythroleukemia, liver, colon carcinoma, among other tissues. Regarding which tissues have PDCD6IP expression, here are a few articles citing expression in various tissues:
Brain, Pubmed ID: 10718198
Cervix carcinoma, Pubmed ID: 18669648, 20068231
Cervix carcinoma, and Erythroleukemia, Pubmed ID: 23186163
Colon carcinoma, Pubmed ID: 24129315
Liver, Pubmed ID: 24275569
Lymph, and Testis, Pubmed ID: 15489334
Melanoma, Pubmed ID: 17081065
Placenta, Pubmed ID: 14702039
Boster Scientific Support
Answered: 2015-11-04





